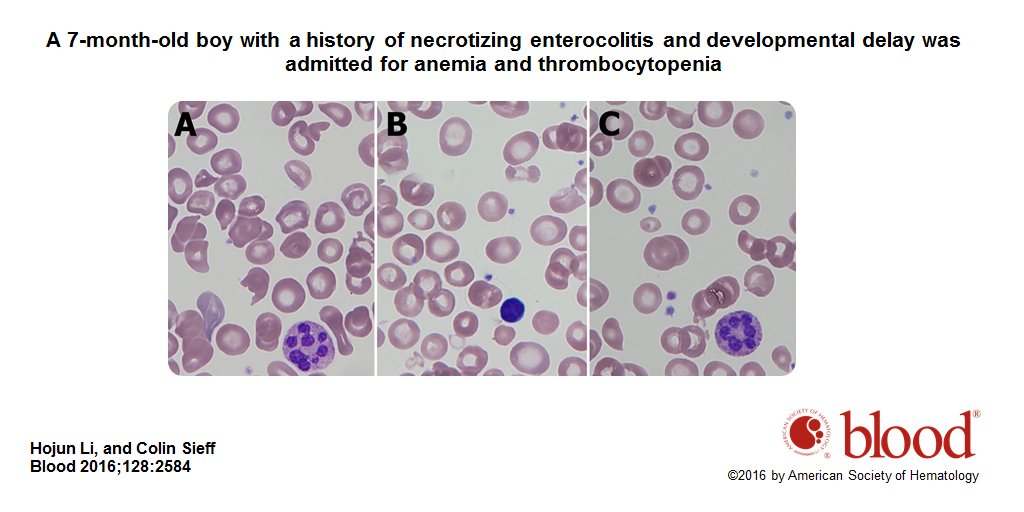

Tweets
- Tweets
- Tweets & replies
- Media
@BloodJournal is blocked
Are you sure you want to view these Tweets? Viewing Tweets won't unblock @BloodJournal.
-
Make sure to pick up a free copy of Blood’s Sickle Cell Disease Compendium at the ASH store
#ConquerSCD#ASH16pic.twitter.com/akJYcxMZbb
-
Don’t miss EIC, Bob Löwenberg, How to get published in a peer review journal. Tomorrow at 11:15 AM http://ow.ly/dsJa306KmfG
#ASH16pic.twitter.com/OVOkmPNK1L
-
Kudos to
@ASH_hematology@BloodJournal for launch of new hematology journal & perfect new Twitter handle :@BloodAdvances !#ASH16pic.twitter.com/hEnUDhOs6k
-
Thank you for celebrating 70 years with Blood, the #1 cited journal in
#hematology by Journal Citation Report -
Review Article: Pure red cell aplasia http://ow.ly/oucF306q8HT pic.twitter.com/G0ai8CK1ch

-
Blood Work: Characteristic peripheral blood smear findings in disorders of cobalamin metabolism http://ow.ly/z6Ed306q93l
@BostonChildrenspic.twitter.com/pwhuFoGb0s
-
Inside Blood Commentary: Novel antivirals for HCV-associated lymphomas http://ow.ly/2iQx306q8z6
-
Interferon-free antiviral treatment in B-cell lymphoproliferative disorders assoc. with HCV infection http://ow.ly/huyE306q8j0 pic.twitter.com/B9UqqxH3DH

-
Inside Blood Commentary: Sickle cell disease: the price of cure http://ow.ly/gl6R306q86X
#SCD#transplantation -
First prospective trial of unrelated donor marrow
#transplantation in children with sickle cell disease http://ow.ly/sFNZ306q7Tr#SCDpic.twitter.com/vCyZti6gmh
-
Inside Blood Commentary: Glycans of plasma ADAMTS13 http://ow.ly/s9LF306q7Id
#thrombosis -
Identification of the glycosylation site on plasma ADAMTS13 http://ow.ly/5DIq306q72j
#thrombosispic.twitter.com/WwcZlADsJZ
-
Inside Blood Commentary: Pericytes: new EPO-producing cells in the brain http://ow.ly/GG0M306q6RU
@NorthwesternU -
Brain pericytes as oxygen sensors and a source of erythropoietin http://ow.ly/6hEw306q6Iq pic.twitter.com/QGQrGVVKsB

-
Blood Work: Pseudo Chediak-Higashi anomaly in acute monoblastic
#leukemia http://ow.ly/LScj306q6ks pic.twitter.com/r5nZEiBqIp
-
Blood Flashback 1977: Stimulation by HPCM of hemopoietic colony formation by human marrow cells http://ow.ly/k7tj306q5OO pic.twitter.com/N0NH5CTOrd

-
A role for the Th/Tc17 pathway in GVHD progression http://ow.ly/LYJE306q5EV
#transplantationpic.twitter.com/TNLtXvvFXY
-
Inside Blood Commentary: Is the
#lymphoma better? Not easy to determine http://ow.ly/WyP2306q5wk -
Perspectives: Refined Lugano Classification
#lymphoma response criteria http://ow.ly/RZij306q5my pic.twitter.com/P9YyAqxbbx
Loading seems to be taking a while.
Twitter may be over capacity or experiencing a momentary hiccup. Try again or visit Twitter Status for more information.


 Blood Journal
Blood Journal
 Naveen Pemmaraju, MD
Naveen Pemmaraju, MD